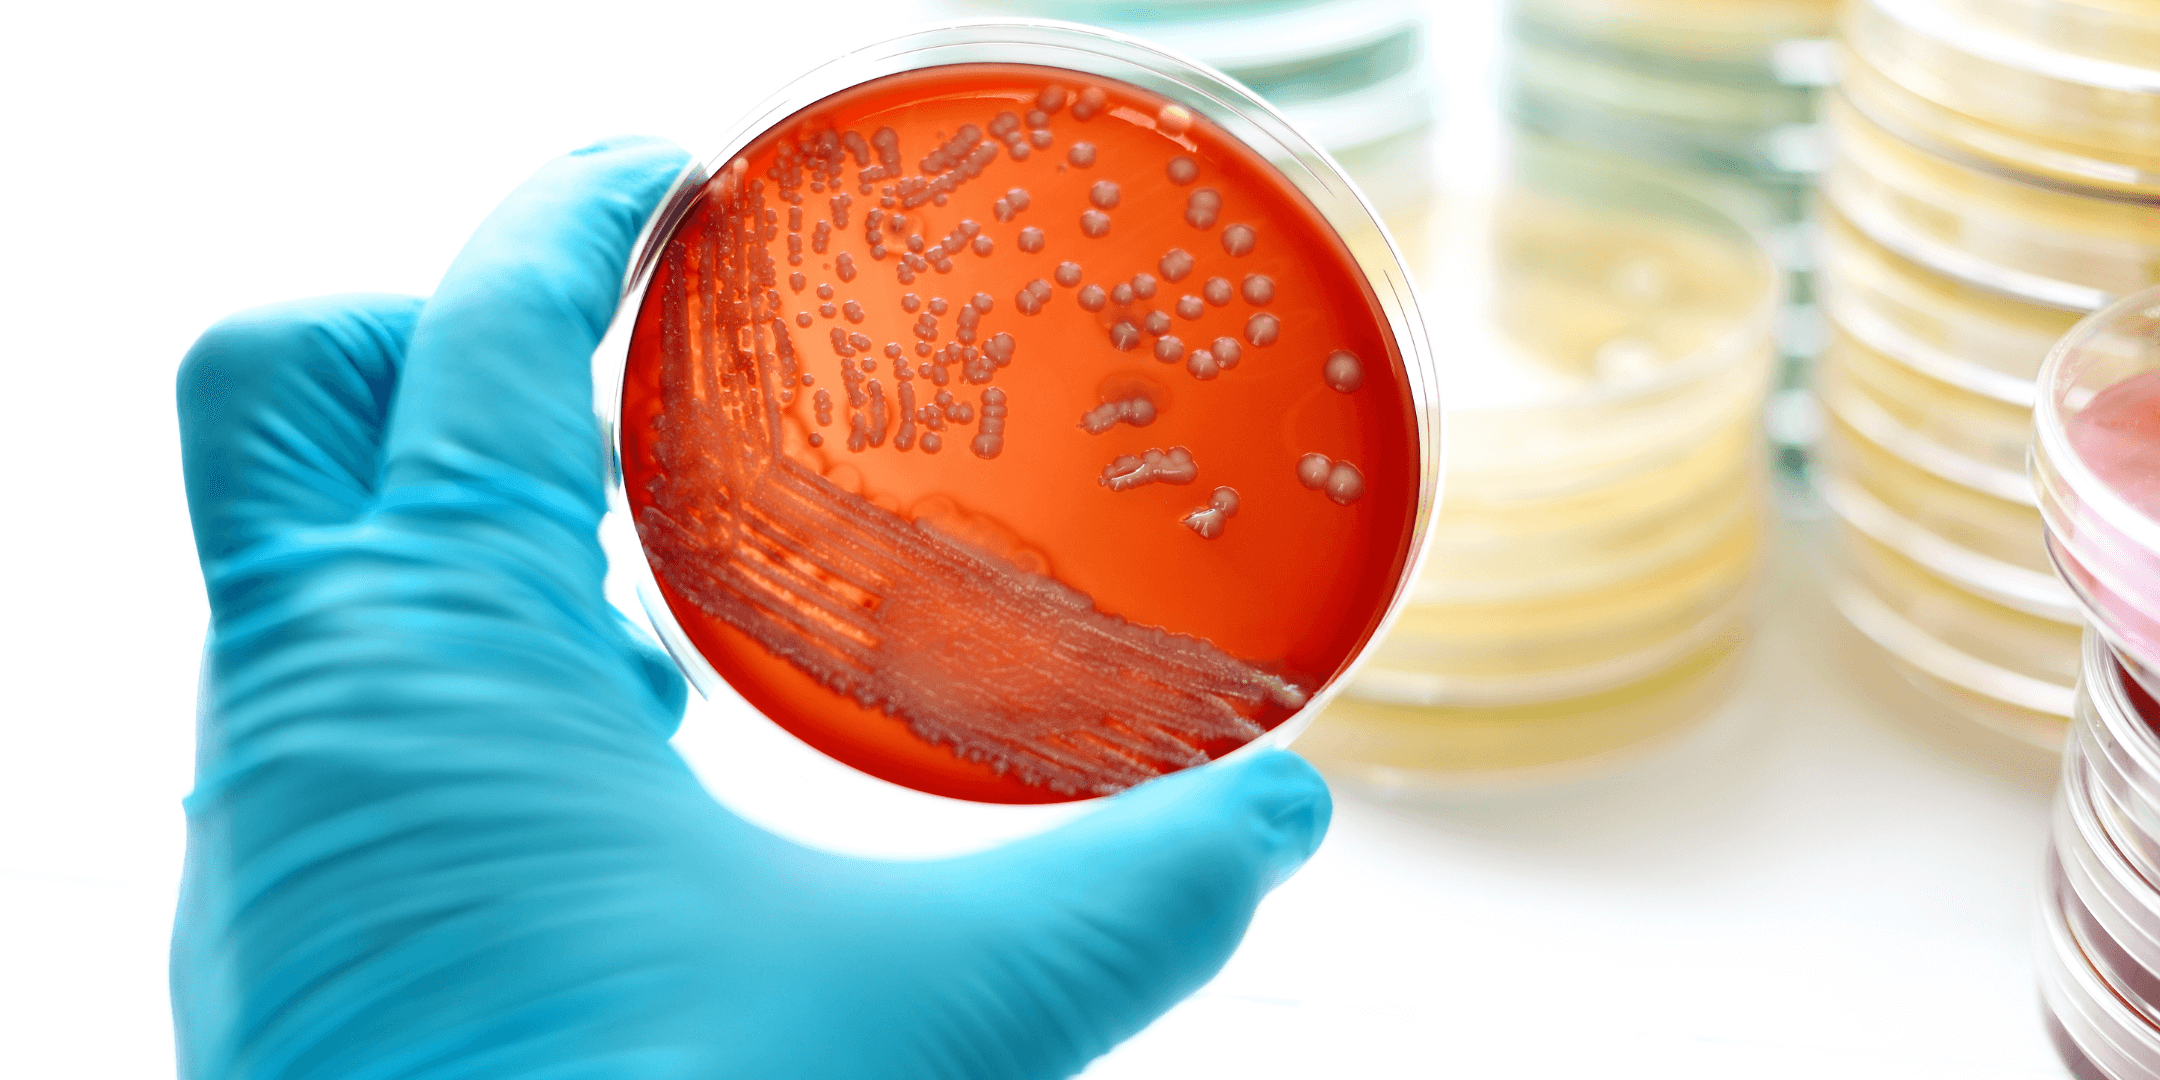
An agar plate with streaks of bacteria held by a gloved hand

You are in preview mode
Investigating the sleeping state in bacteria
Bacteria are tiny microorganisms that have the most amazing strategies to cause disease and survive in their environments. They need nutrients, the right amount of oxygen, light and temperature to survive but what happens when their environment and conditions needed for their existence change? Do they just die?
My job as a research microbiologist is to focus on the ‘bad bacteria’ – the ones that make people sick. In this article, I am going to tell you about some of the tools and tricks that bacteria have to help them survive in the environment and how these tools help the bacteria to cause disease in humans.
Bacteria come in different shapes and sizes, some are rod shaped (bacillus), some are spherical (coccus), some are comma shaped (vibrio), and some are spiral shaped (spirilla). Bacteria can occur in pairs such as diplococci (pneumococcus), in chains such as streptobacilli or streptococci, grape-like bunches such as staphylococci, packets of eight or more are sarcinae and groups of four in a square shape are tetrads. Bacillus bacteria can also form palisades where they resemble a picket fence.
All about my favourite bacteria…
Before I tell you about some of those tricks and tools, let me introduce you to my favourite bacteria. It is called Vibrio. It loves warm temperatures and salty environments. It lives in the marine environment, in seawater or inside shellfish (molluscs), such as oysters and mussels and in crustacean, such as crabs and prawns during the summer months. Vibrio are rod shaped bacteria and they have stealth-like weapons to help them survive in the environment. When people eat shellfish that are contaminated with Vibrio bacteria, the bacteria can use their weapons to cause diarrhoea and vomiting – this is called gastroenteritis. Vibrio bacteria are the leading cause of seafood-associated gastroenteritis worldwide.
Infecting humans
Here are three tools that Vibrio bacteria have to help them to enter the human gut and cause gastroenteritis.
Flagella – (singular is flagellum, plural is flagella).
Flagella look like strands of hair, and they aid bacteria to swim and attach to surfaces. In the turbulent marine environment, bacteria use the flagella to swim, to attach to surfaces such as the insides of shellfish where they can settle and grow. Unfortunately for us, when Vibrio bacteria are eaten by humans, the bacteria use their flagella to swim and make it to the gut, there they further use the flagella to attach to the lining of the gut.
Toxins
Toxins are chemicals produced by the bacteria that can cause a reaction in your body. Once the Vibrio bacteria use their flagella to attach to the gut lining they then produce a type of toxin called enterotoxins. Vibrio bacteria release these enterotoxins only once they enter the human gut. Some Vibrio toxins enter the blood cells and cause them to burst open releasing blood into the lower intestine causing bloody diarrhoea as a symptom of infection. Some Vibrio toxins are released in the gut causing water and salt imbalances, which leads to a rice-water like diarrhoea being produced; this diarrhoea is called cholera and caused by a particular species of Vibrio called Vibrio cholerae.
Siderophores
Bacteria need essential nutrients to grow and survive. Vibrio bacteria need iron to grow and they have developed special tools to scavenge iron from their surroundings. One of those tools are called siderophores. Siderophores allow bacteria to take iron from other bacteria, environmental sources or from iron sources in our bodies such as lactoferrin and transferrin. If they cannot get hold of that iron, the bacteria will not survive very long inside us and the infection is limited.
Some stealthy shape shifting tricks
Vibrio bacteria need salt and warm temperatures to flourish and so we often detect them in summer months when the conditions are perfect for them to grow. Vibrio bacteria are not detected in the marine environment in the winter months and it is assumed they die due to the cold temperatures and the lack of nutrients. The following summer the Vibrio bacteria will reappear to inhabit the environment and cause seasonal infections once more. So the question is – do Vibrio bacteria really die in the winter?
In laboratory experiments, we can show that some cells of Vibrio bacteria enter a state of dormancy or a sleep-like behaviour in order to survive cold temperatures and low nutrient levels. If we take those dormant sleeping Vibrio and put them into warm temperatures and nutrient rich conditions they reawaken and reproduce once more. Is this happening in the environment too? Do Vibrio bacteria survive in the winter by hibernating until the following summer?
As a research scientist, the topic of bacterial dormancy is both fascinating and a complex subject to investigate.
So how do I study them?
In the laboratory, I can put Vibrio bacteria into a sleep like state by placing them under cold temperatures and taking away their food sources. Many of these bacteria die in these harsh conditions but I have found that some Vibrio cells enter a state of dormancy. How do I know this? I use a special piece of machinery called a flow cytometer to look at all the cells as I put them to sleep.
Here is a bit about how it works: I take a sample that has a mixture of cells of varying sizes and shapes (such as a food or water sample) and examine the microscopic contents using the flow cytometer. The machine takes the sample and passes each single particle, one at a time through a small capillary. As each particle passes through the capillary, a light shines upon it and the computer measures the way in which the light scatters as it hits each cell. For example, light will hit and radiate off a round-shaped particle very differently to when light hits a rod shaped particle. The different ways the light scatter means that, I can separate particles and bacteria depending on their shape and size.
Using the flow cytometer, I have found out that dormant Vibrio bacteria look quite different to healthy, alive, awake Vibrio bacteria. When Vibrio bacteria are healthy, they are rod shaped and approximately 1µm in size. When they are lying dormant, they change shape and turn coccoid or spherical in shape. They also balloon out and increase in size. These dormant bacteria utilise nutrients at a reduced rate and are conserving their energy to a bare minimum. They do not divide or grow in this dormant state so they can save energy and resources. This state of dormancy is reversible and if I put the dormant bacteria into warm nutrient rich conditions than they wake up and start growing once more.
Why do I study them?
When microbiologists examine food and clinical samples for the presence of microbes they typically measure the bacteria that are actively growing and dividing. Because dormant cells do not grow and use little energy, they are much harder to detect and evade our conventional microbe detection tests. Researching bacterial dormancy is going to be important in developing new ways to detect these dormant cells so we can detect them before they wake in food and medical samples. If I can detect Vibrio bacteria before they wake up in the summer this could help prevent gastroenteritis infections from occurring in the first place.
I am also investigating if Vibrio bacteria are present naturally in in the environment during the winter. In my future research, I hope to look at these dormant bacteria in nearshore ecosystems inside oysters. I want to find out how they adapt from favourable conditions in the summer to more unfavourable conditions in the winter? What mechanisms do dormant cells use to cope with the changing environment? What tools do they have that allow them to become dormant cells? These are all important questions that I hope to answer one day.
Additional information
Find out more
Please note that the below links open in a new tab
My staff profile on the University of Exeter website
A blog article about my latest research on dormant bacteria
Soapbox Science – is a public event that showcases research by female scientists, events are held all over the country during the summer including Exeter for which I am one of the organisers. Check out an event near you so you can listen to some great science!
About the author
I am a British Muslim Asian who originally grew up in Luton, Bedfordshire. I love sports and am quite active. My friends at the University of Exeter taught me to ride a bike at age 26 and you now might see me cautiously cycling around Somerset with my two children.
My research is important to prevent infections or treat diseases. It’s incredibly fun and I love going to work to see how my experiments are going. I get to use cutting-edge technology and the latest techniques to investigate bacteria and find out things no one else does yet. My 10-year-old son often asks ‘when I will finish my experiments on sleeping bacteria?’. But my answer is there is always something new to find out and discover about these bacteria that my research doesn’t really stop!
Page
Research Placements & Experiences
Our placements give you the chance to gain real-life workplace experience in the STEM sector while you develop your research skills and industry knowledge.
Page
Online Mentoring
Not sure what to do after Year 13? Talk to one of our free STEM Mentors to help you explore future career options.
National STEM Learning Centre, University of York, York YO10 5DD. 01904 328300
© STEM Learning Ltd. is a not-for-profit company (05081097)
